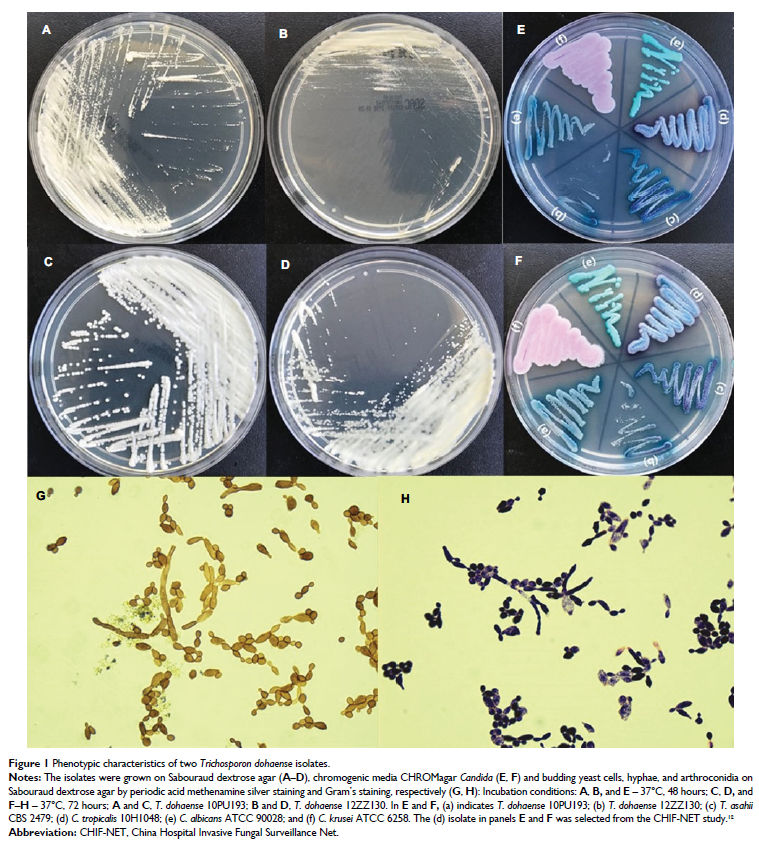

-
Original Research

- 作者:吴雪平,刘磊,郭亚玲,杨丽娟
- 期刊:International Journal of Nephrology and Renovascular Disease
-
Original Research
- 作者:Shu-Ying Yu, Li-Na Guo, Meng Xiao, Timothy Kudinha, Fanrong Kong, He Wang, Jing-Wei Cheng, Meng-Lan Zhou, Hui Xu, Ying-Chun Xu
- 期刊:Infection and Drug Resistance
-
Original Research

- 作者:Wenbin Zhou, Yayuan Zhang, Caineng Zhong, Jintao Hu, Hong Hu, Dongxian Zhou, MeiQun Cao
- 期刊:Cancer Management and Research
-
Original Research

- 作者:Chuchu Zhao, Ermei Lu, Xiaoli Hu, Huihui Cheng, Jian-An Zhang, Xueqiong Zhu
- 期刊:Cancer Management and Research
-
Original Research

- 作者:Huanli Luo, Yanan He, Fu Jin, Dingyi Yang, Xianfeng Liu, Xueqi Ran, Ying Wang
- 期刊:Cancer Management and Research
-
Original Research

- 作者:Yu Zhang, Shu-wei Chen, Li-li Liu, Xia Yang, Shao-hang Cai, Jing-ping Yun
- 期刊:Cancer Management and Research